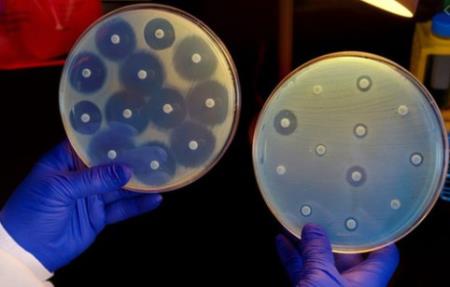
Cannabidiol giúp chống lại vi khuẩn kháng thuốc

Bác sĩ Anh giải thích chuyện gì xảy ra trong phòng chăm sóc tích cực và nhắc nhở về thứ 'quyền năng' hơn để cứu bệnh nhân Covid-19
Rất nhiều bệnh nhân nhiễm Covid-19 với tình trạng nặng đã được chuyển vào đơn vị chăm sóc tích cực (ICU). Ngay cả Thủ tướng Anh sau khi nhiễm virus cũng từng nằm ở căn phòng đặc biệt này trong hơn 2 n...